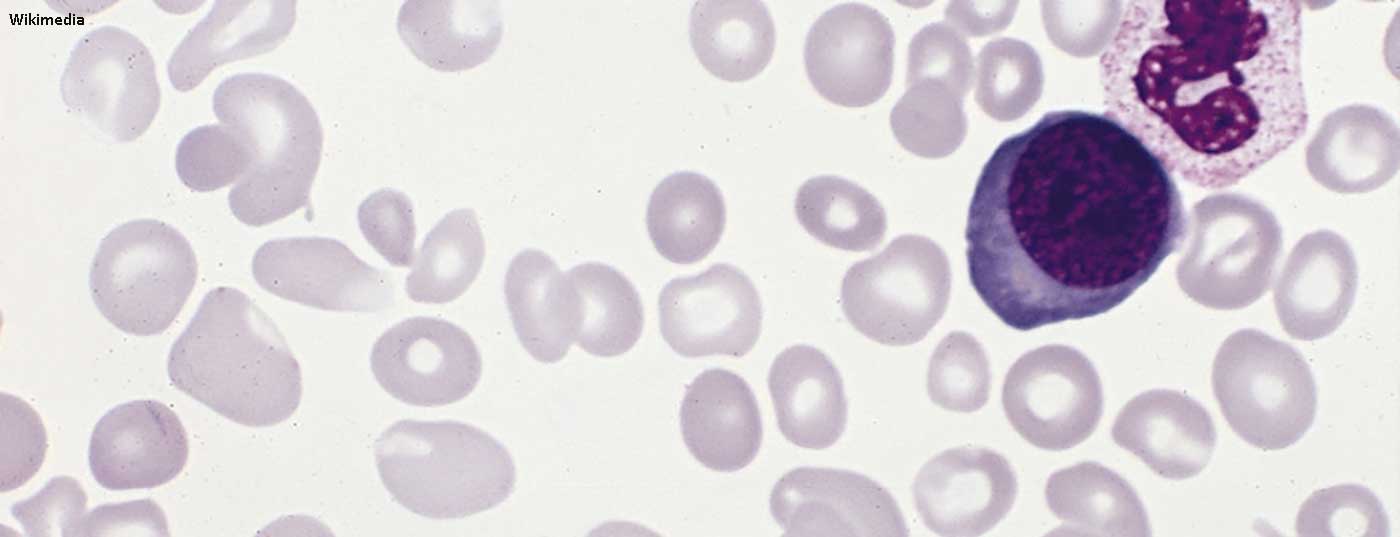
polycythemia_vera_blood_smear

Durch Hyperproliferation der drei Zellreihen im Knochenmark kommt es bei der Polycythaemia vera zu Erythrozytose, Thrombozytose und Leukozytose. Folge ist u.a. ein deutlicher Anstieg der Hämatokritwerte und damit ebenso des Risikos für thromboembolische Ereignisse. Mit Acetylsalicylsäure (ASS), Phlebotomien und zytoreduktiven Substanzen stehen mehrere Optionen zur Verfügung, um eine Thrombose zu vermeiden. Doch welche ist wann indiziert?